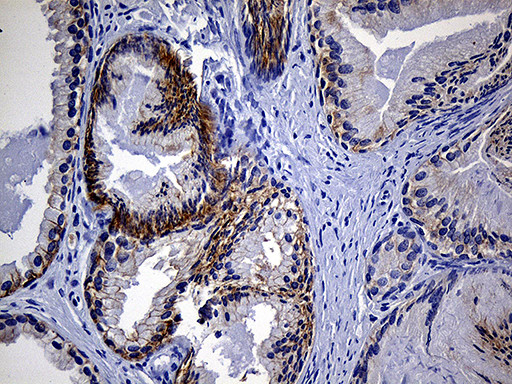
EGF Antibody in Immunohistochemistry (Paraffin) (IHC (P))

Search
OriGene
EGF Monoclonal Antibody (OTI2F9), TrueMAB™
{{$productOrderCtrl.translations['antibody.pdp.commerceCard.promotion.promotions']}}
{{$productOrderCtrl.translations['antibody.pdp.commerceCard.promotion.viewpromo']}}
{{$productOrderCtrl.translations['antibody.pdp.commerceCard.promotion.promocode']}}: {{promo.promoCode}} {{promo.promoTitle}} {{promo.promoDescription}}. {{$productOrderCtrl.translations['antibody.pdp.commerceCard.promotion.learnmore']}}
产品信息
TA811546
种属反应
宿主/亚型
分类
类型
克隆号
抗原
偶联物
形式
浓度
纯化类型
保存液
内含物
保存条件
运输条件
靶标信息
EGF (Epidermal growth factor) exerts its actions by binding to the EGF Receptor, a 170 kDa protein kinase. Activation of EGFR initiates diverse cellular pathways in response to toxic environmental stimuli, or to EGF binding to the receptor, the EGFR forms homo- or heterodimers with other family members. Each dimeric receptor complex initiates a distinct signaling pathway by recruiting different Src homology 2 (SH2) containing effector proteins. EGF is far and wide expressed in kidney, cerebrum, prostrate and salivary glands. EGF acts as a potent mitogenic factor and the phosphorylated receptor recruits adapter proteins like GRB2 that activates complex downstream signaling cascades. EGF activates at least 4 major downstream signaling cascades including the RAS-RAF-MEK-ERK, PI3 kinase-AKT, PLCgamma-PKC and STAT modules. Research studies suggest the protein may also play important role in activating the NF-kappa-B signaling cascade. Defects in the EGGF gene are the cause of hypomagnesemia type 4 and dysregulation has been associated with the growth and progression of certain cancers.
仅用于科研。不用于诊断过程。未经明确授权不得转售。
篇参考文献 (0)
生物信息学
蛋白别名: beta-urogastrone; EGF; Epidermal growth factor; H-EGF; Pro-epidermal growth factor
基因别名: EGF; HOMG4; URG
UniProt ID: (Human) P01133
Entrez Gene ID: (Human) 1950